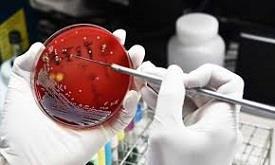

Current Affairs September 2019 - International
1 - Sri Lanka signed four agreements with Maldives

Maldives and Sri Lanka have exchanged an Agreement of Cooperation and three Memoranda of Understanding. They are −
facilitation of visa arrangements allowing for free 90-day on-arrival visas for visitors between the two countries.
an MoU on Cooperation in the area of Social Protection to provide support and protect vulnerable members of society, including children, the elderly and persons with disabilities.
an MoU on Higher Education to expand education opportunities for students of both countries.
an Mou on Vocational Training and Youth Development to increase knowledge and experience sharing pertinent to helping youth develop their social and leadership skills.
2 - Indonesia to move capital from Jakarta to East Kalimantan

Indonesian President Joko Widodo announced that the country’s capital will move from Jakarta to a site in East Kalimantan province on Borneo island. Jakarta is the centre of government, business, finance, trade and services.
Jakarta is home to 10 million people, and is overcrowded and heavily polluted. It is prone to earthquakes and flooding, and parts of the city are sinking as much as 25cm a year as a result of subsidence. The Borneo Island is known for rainforests and orangutans.
3 - India, US agree to pursue collaboration between their defence industry & start-ups

Indian and US officials have agreed to pursue a policy environment conducive to collaboration between the defence industry and start-ups in both countries. An understanding in this regard was reached during the 15th meeting of the India-US Defence Policy Group (DPG) in Washington.
The Defence Policy Group or DPG is the top official-level meeting mechanism between India and the US on defence issues, which comprehensively reviews and guides all aspects of bilateral cooperation between the two countries.
4 - Netherlands bans face-covering clothing

The Netherlands banned face-covering clothing, such as a burqa or niqab, in public buildings and on transport. The Netherlands is the latest European country to introduce such a ban, following the likes of France, Germany, Belgium, Austria and Denmark.
The legislation also applies to other face coverings such as full-face helmets, balaclavas or ski mask. France was the first European nation to ban the public use of veils, both face-covering niqabs and full-body burqas.
5 - 10th Mekong Ganga Cooperation Ministerial Meeting held in Bangkok

The 10th Mekong Ganga Cooperation (MGC) Ministerial Meeting was held in Bangkok, Thailand. External Affairs Minister S Jaishankar represented India.
The Ministers adopted the new MGC Plan of Action 2019-2022 that envisages project-based cooperation in the seven areas of MGC cooperation, namely tourism and culture, education, public health and traditional medicine, agriculture and allied sectors, transport and communication, MSMEs as well as three new areas of cooperation, i.e. water resources management, science and technology, skill development and capacity building.
6 - India, South Korea sign two major agreements

India and South Korea signed two memorandum of understanding (MoU) to further defence educational exchanges and extend logistical support to each other’s Navies.
The logistics agreement will help the Indian Navy in interoperability, especially when it operates in the Indo-Pacific Region in the ports of South Korea. The agreements were signed after the talks between Defence Minister Rajnath Singh and his South Korean counterpart Jeong Kyeongdoo in Seoul.
7 - South Africa temporarily closed its diplomatic missions in Nigeria

South Africa has temporarily closed its diplomatic missions in Nigeria following reprisal attacks by Nigerians triggered by xenophobic violence in South Africa. Nigeria too introduced plans to evacuate its nationals from South Africa following a wave of attacks on foreigners.
South African-owned businesses were targeted by protesters in several Nigerian cities as a reprise to the killing of Nigerians in South Africa. Rioting in South Africa against foreign businesses has killed at least many people in Johannesburg and Pretoria.
8 - India Pavilion inaugurated at the 44th Toronto International Film Festival 2019

High Commissioner of India to Canada, Vikas Swarup, inaugurated the India Pavilion at the 44th Toronto International Film Festival (TIFF) 2019. It will provide a platform to showcase Indian Cinema in the overseas market and facilitate new business opportunities.
IFFI 2019 poster and brochure were also released on the ocassion. The year 2019 marks the Golden Jubilee Edition of IFFI which is to be held in Goa later this year. TIFF provides ideal platform for global outreach of 50th IFFI 2019.
9 - Defense Minister Rajnath Singh addressed 8th Seoul Defense Dialogue in South Korea

Union Defense Minister Rajnath Singh delivered the keynote address at Plenary session of the 8th Seoul Defense Dialogue in Seoul, Republic of Korea. The theme of Defence Dialogue was- ‘Building Peace Together: Challenges and Vision’.
The Seoul Defense Dialogue was launched in 2012 as a vice ministerial level multilateral security consultation regime for talks on Asia-Pacific cooperation and peace on the Korean Peninsula.
10 - US Federal Trade Commission fines YouTube with $170 million

Google LLC and its subsidiary YouTube was fined with $170 million by US's Federal Trade Commission for violating Children’s Online Privacy Protection Act (COPPA). YouTube earned millions by illegally tracking viewers of children's channels using cookies without their parents’ consent and used those cookies to deliver millions of dollars in targeted advertisements. Cookies track user behavior across the internet.
As per COPPA act, it is required to obtain parental consent for collecting information on children under age 13 from child-directed sites to disclose data practices.
11 - Russia, Ukraine exchange prisoners

Russia and Ukraine have completed a long-awaited exchange of prisoners between them. A total of 70 prisoners were involved in this landmark exchange. This is the first major exchange of prisoners between Russia and Ukraine since the conflict over eastern Ukraine erupted in 2014.
It could be a crucial step in easing tensions between the ex-Soviet neighbours over Russia's annexation of Crimea and the subsequent war that has left more than 13,000 dead in Donetsk and Luhansk regions.
12 - College building, constructed with Indian aid, inaugurated in Kathmandu

Indian Ambassador to Nepal, Manjeev Singh Puri, inaugurated a new building of Koteshwor Multiple Campus in Kathmandu. It was constructed with the Government of India’s grant assistance of 45.10 million Nepali rupees. The new three-storey building comprises 18 classrooms and separate sanitation facilities for boys and girls among other facilities.
Koteshwor Multiple Campus, established in 1990, is a non-profitable non-governmental, service-oriented community college situated at Koteshwor in Kathmandu district. The Campus has over 3,700 students, about 60% of whom are girls.
13 - Iran fired up advanced centrifuges in latest nuclear step

Iran has fired up advanced centrifuges to boost its enriched uranium stockpiles. According to the Atomic Energy Organisation of Iran, it had activated 20 IR-4 and 20 IR-6 centrifuges.
The move could lead to Tehran enriching uranium much faster and gaining the means to build atom bombs. Under the 2015 Joint Comprehensive Plan of Action (JCPOA), Iran was allowed to enrich uranium, using only first-generation or IR-1 centrifuges.
14 - Amazon countries meet to bolster rainforest protection

Presidents and Ministers from seven Amazon countries met in Colombia to take measures on protecting the world's biggest rain-forest from wildfires and rampant deforestation. The representatives of the seven nations signed the "Leticia Pact for the Amazon".
The new measures include the establishment of an "Amazonian cooperation network" to share information on deforestation, including weather data to mitigate the effects of climate change, and threats from illegal mining and logging.
15 - US states announced antitrust probe of Facebook

A coalition of US states announced an antitrust investigation of Facebook to determine if the social media giant has hindered competition and put users at risk. The states include - New York state, District of Columbia, Colorado, Florida, Iowa, Nebraska, North Carolina, Ohio and Tennessee.
The move marks the first official US antitrust action against one of the big tech companies -- although a landmark case had targeted Microsoft back in the 1990s.
16 - Argentina invites India for Mar del Plata Film Festival and Ventana Sur 2019

The Instituto Nacional de Cine y Artes Audiovisuales (INCAA) has invited India for the Mar del Plata Film Festival and Ventana Sur 2019. INCAA is the National Institute of Cinema and Audiovisual Arts in Argentina.
The Mar del Plata International Film Festival will be held between November 9 and November 18. The Indian delegation met the Argentine delegation at the Toronto International Film Festival (TIFF) 2019 as part of the outreach for the Golden Jubilee edition of International Film Festival of India (IFFI).
17 - India hosts 6th India-China Strategic Economic Dialogue

India hosted the three-day 6th India-China Strategic Economic Dialogue in New Delhi from 7-9 September. It is an annual event attended by NITI Aayog of India and National Development and Reforms Commission (NDRC) of China. It is held alternatively in New Delhi and Beijing.
The dialogue comprised of round table meetings of joint working groups (JWG) on infrastructure, energy, high-tech, resource conservation, pharmaceuticals and policy coordination. The bilateral trade between the countries stood at USD 87 billion in 2018-19. The trade deficit stood at USD 50 billion in favour of China.
18 - 4th Indian Ocean Conference 2019 held in Male

4th Indian Ocean Conference 2019 was recently held in Male, Maldives. The theme of the two-day conference was ‘Securing the Indian Ocean Region: Traditional and Non-Traditional Challenges’. Indian External Affairs Minister S. Jaishankar was one of the speakers at the event.
The conference was chaired by Sri Lankan Prime Minister Ranil Wickremesinghe and it was organised by India Foundation (based in New Delhi), in association with Government of Maldives and S Rajaratnam School of International Studies (RSIS) in Singapore.
19 - 5th Eastern Economic Forum (EEF) held in Vladivostok

The 5th edition of the Eastern Economic Forum (EEF) was held in Vladivostok, Russia from September 4-6. It was aimed at providing a platform for discussing issues aimed at expanding international cooperation in Asia-Pacific region and developing the economy of Russia's Far East.
The participants in Summit were India, Malaysia, Japan, Australia, and South Korea. India’s Prime Minister Narendra Modi was Chief Guest at the event being hosted by Russian President Vladimir Putin. EEF is annual event held at Vladivostok, Russia to encourage foreign investment in the Russian Far East.
20 - Heartland International Film Festival, USA to explore “Special Focus on India”

The Indian Delegation met prominent representatives from the International Film Fraternity on the third day of Toronto International Film Festival 2019. The discussions included participation at the Golden Jubilee Edition of IFFI, possibility of taking forward Government thrust of “Ease of filming in India”, recent initiatives to promote film facilitation etc.
Ms Hannah Fisher, Programming Head of Heartland International Film Festival of USA discussed the possibility of special focus on India for the Festival commencing from 10th October 2019 under the ‘Foreign Language Category.
21 - India announced USD 1 million humanitarian aid for Bahamas

India announced a humanitarian assistance of USD 1 million to help people in the Bahamas affected by Hurricane Dorian. Hurricane Dorian the fifth tropical cyclone devastated the northwestern Bahamas and caused significant damage to the Southeastern United States and Atlantic Canada. The death toll from the calamity has risen to over 40 and at least 70,000 people were left homeless.
Hurricane Dorian is the first major hurricane of the 2019 Atlantic hurricane season and had caused property damages of $7 billion to the Bahamas.
22 - India participated in Thessaloniki International Fair in Greece

An Indian delegation led by Minister of State (MoS) for Commerce and Industry, Hardeep Singh Puri participated in the 84th Thessaloniki International Fair (TIF) in Greece. The Minister of State for Commerce and Industry highlighted the prospects for the development of Indian business in Greece and the wider region of Southeast Europe to strengthen bilateral trade relations between the two countries.
During the TIF Fair a large number of exhibitors from ISRO, National Thermal Power Corporation (NTPC), Agricultural Produce Export Development Authority (APEDA), companies from MSMEs and tiles and ceramics industry.
23 - 7th RCEP Ministerial Meeting Held in Bangkok

Union Minister of Commerce & Industry and Railways PiyushGoyal participated in 7th RCEP Ministerial Meeting held in Bangkok, Thailand. The Ministers from the 16 RCEP Participating Countries (RPCs) gathered in Bangkok to review developments in the RCEP negotiations and recognised that negotiations have reached a critical milestone. RCEP will provide the much-needed stability and certainty to the market, which will in turn boost trade and investment in the region.
The Ministers made the collective call to negotiators to handle uncertainties in trade and investment environment.
24 - Motihari-Amlekhganj (Nepal) pipeline inaugurated by PM Modi and PM Oli of Nepal

PM Modi and PM Oli of Nepal jointly inaugurated a cross-border petroleum products pipeline. It is South Asia’s first cross-border petroleum products pipeline from Motihari in India to Amlekhgunj in Nepal. 69-km Motihari-Amlekhgunj pipeline, having a capacity of 2 million metric ton per annum, will provide cleaner petroleum products at affordable cost to the people of Nepal.
Prime Minister Oli announced to reduce the price of petroleum products by Rs. 2 per litre in Nepal. The consumers on both sides are set to benefit from the reduction in costs once this pipeline becomes operational.
25 - India and Iceland signed agreements

India and Iceland signed agreements to enhance cooperation in the field of sustained fisheries development and organise cultural exchange programme between 2019 and 2022. Iceland also declared exemption from Visa for Indian diplomatic and official passport holders. The agreements and MoUs were signed in the presence of President Ram Nath Kovind and his Iceland counterpart Gudni Johannesson in Reykjavik in Iceland.
Iceland was invited to be part of the international solar alliance led by India to promote solar energy worldwide.
26 - North Korea confirmed 2nd test of multiple rocket launcher

North Korea confirmed test-launch of a "super-large multiple rocket launcher" system, the latest in a series of weapons tests performed by Pyongyang amid stalled diplomacy over its nuclear programme. It was the second known test of a super-large multiple rocket launcher, needed to cope with outside military threats. The first test of the weapon occurred in August 2019.
North Korean leader Kim Jong Un supervised the two rounds of test-firings at an unidentified place. The unidentified projectiles launched by North Korea flew approximately 330 kilometres.
27 - Scotland Court ruled Boris Johnson's suspension of parliament as unlawful

Scotland’s highest civil court has ruled that British Prime Minister Boris Johnson’s suspension of the UK Parliament is unlawful. A panel of three judges at the Court of Session gave the ruling in favour of a cross-party group of politicians.
Court of Session judges unanimously called Prime Minister's decision to suspend Parliament was motivated by improper purpose of stymying Parliament. MPs are not currently scheduled to return to Parliament until 14 October, when there will be a Queen's Speech outlining Mr Johnson's legislative plans. The UK is due to leave the EU on 31 October.
28 - US Prez Trump issued new executive order to combat terrorism

United States President Donald Trump has issued a new executive order on the eve of the 9/11 terror attacks eighteenth anniversary that would enhance the country's ability to target terrorists and those who finance their activities to deter perpetrators of terrorism worldwide. Utilizing the new order, the Treasury sanctioned over two dozen individuals and entities from 11 terrorist groups.
It allows the US Government to better target terror group leaders and provides new tools to pursue individuals who participate in terrorist training.
29 - New satellite images show increase in air pollution in Amazon after fires

New satellite images published by the European Space Agency show an increase in air pollution in the Brazilian Amazon while fires burned in the region in August. Several maps showed more carbon monoxide and other pollutants increased in September as compared to August. Fires released carbon dioxide once stored in the Amazon forests back into the atmosphere, potentially having an impact on the global climate and health.
Data from Brazil's National Institute for Space Research showed the number of fires in all of Brazil has surpassed 1 Lakh in 2019, up by 45% than 2018.
30 - 24th World Energy Congress began in Abu Dhabi

The 24th World Energy Congress commenced in Abu Dhabi under the patronage of Sheikh Khalifa bin Zayed Al Nahyan, President of the United Arab Emirates. The theme ‘Energy for Prosperity’ represents the ambitious and dynamic energy transition of the country.
The four-day World Energy Congress aimed to bring together international energy stakeholders, including governments, private and state corporations, academia and media. With over 15,000 participants expected, the Congress welcomed over 250 high-level speakers, 72 Ministers, 500 CEOs, 1000 media persons with 40,000 square-metre exhibition space that covered the entire energy spectrum.
31 - Saudi Arabia appointed Prince Abdulaziz bin Salman as new Energy minister

Kingdom of Saudi Arabia appointed Prince Abdulaziz bin Salman as its new Energy minister, one of the most important positions in the government. He replaced the long time oil industry veteran Khalid Al Falih.
Prince Abdulaziz is the son of the King of Saudi Arabia. He had earlier served as the Deputy and State Energy Minister for several years. It is the first time a member of the ruling Al Saud family has held the energy minister post in the world’s top oil exporter.
32 - FATF evaluated Pakistan's compliance on its 27-point action plan in Bangkok

The Asia-Pacific Group, the regional affiliate of the FATF evaluated Pakistan's compliance on its 27-point action plan in Bangkok. The exercise is a prelude to Pakistan's final review by the FATF, the working group meeting scheduled for October 13-18 in Paris.
FATF has already put it on notice in its Grey list. The Asia Pacific Group held its last meeting in Canberra on 23rd August and found that Pakistan was non-compliant on 32 of the 40 parameters of terror financing and money laundering. Pakistan could not convince the 41-member plenary to upgrade it on any parameter.
33 - 22nd Session of UN Committee on CRPD held at Geneva

The 22nd Session of UN Committee on Convention on Rights of Persons with Disabilities was held at Geneva. The UN Committee on CRPD in its 22nd Session took up India’s First Country Report for consideration.
India is a signatory of the United Nations Convention on Rights of Persons with Disabilities (UNCRPD). It ratified this Convention on 01-10-2007 in pursuance of Article 35 of the Convention. India submitted its First Country Report on Status of Disability in India in November 2015.
34 - India joined the Global Antimicrobial Resistance Research and Development Hub

India joined the Global Antimicrobial Resistance (AMR) Research and Development (R&D) Hub as a new member. This expands the global partnership working to address challenges and improve coordination and collaboration in global AMR R&D to 16 countries, the European Commission, two philanthropic foundations and four international organisations (as observers).
The Global AMR R&D Hub was launched in May 2018 in the margins of the 71st session of the World Health Assembly. The Global AMR R&D Hub supports global priority setting and evidence-based decision-making on the allocation of resources for AMR R&D.
35 - Global leaders call for urgent action on Climate adaptation at concluding day of Cop 14

At the closing of the 14th Conference of Parties under the United Nations Convention to Combat Desertification, global leaders called for urgent action on Climate adaptation. The 'Delhi Declaration' will also be adopted by the parties.
The 12-day Conference witnessed quality dialogues and stronger partnership to address land degradation and mitigating climate change. The core agenda of the Conference was to reverse land degradation and its outcomes while accelerating positive achievements for people and for ecosystems.
36 - UAE Prez bestows First Class Order of Zayed II award to Navdeep Singh Suri

UAE President Sheikh Khalifa bin Zayed Al Nahyan has bestowed the First Class Order of Zayed II award to the outgoing Indian Ambassador, Navdeep Singh Suri, for his contribution to the development and strengthening of friendly relations and co-operation between the two friendly countries.
The award is given in recognition of his contribution to the development and strengthening of friendly relations and co-operation between the two countries. It is a rare honour given to any diplomat. Suri has been heading the Indian mission in the UAE since October 2016.
37 - Pakistan likely to miss IMF's tax refund condition

Cash strapped Pakistan is set to miss the International Monetary Fund's condition to refund Rs. 75 billion to taxpayers despite an incentive by the global lender. The International Monetary Fund (IMF) had offered to soften the tough primary budget deficit reduction target if the country performs better in tax refunds.
Under the IMF's six-billion-dollar loan deal, Pakistan is required to reduce the primary budget deficit, calculated by excluding interest payments, to Rs. 276 billion in the current fiscal year 2019-20 from last year's level of Rs. 1.350 trillion.
38 - Thailand becomes 1st country in Asia to roll out plain cigeratte packaging

Thailand became the first country in Asia to roll out plain cigarette packaging to reduce the appeal of smoking. Australia was the first country to have made such law to require tobacco products to be sold without colourful brand logos in 2012.
Plain packaging was included in guidelines to the WHO Framework Convention on Tobacco Control (WHO FCTC). On 31 May 2016, on World No Tobacco Day, the WHO called on governments to get ready for plain packaging of tobacco products.
39 - Vietnam opens Southeast Asia’s largest solar power farm

Vietnam inaugurated Southeast Asia's largest solar power farm, The Dau Tieng Solar Power Complex, which has the capacity to produce 688 million kWh of electricity annually. The Dau Tieng Solar Power Complex which is a joint venture with the Thai industrial group B.Grimm Power Public Company, has an investment of more than $391 million.
Southeast Asia's largest solar power farm is expected to generate 10% of the country's solar energy to guarantee supply to 320,000 homes and can prevent the emission of 595,000 tons of carbon dioxide into the atmosphere every year.
40 - Sri Lanka flagged off Pulathisi Express, a ‘Make In India’ train

Sri Lanka flagged off Pulathisi Express, a 'Make In India' train, from Colombo Fort Railway station. The rake of the train was manufactured in the Integral Coach Factory (ICF) in Chennai. It has been inducted under an Indian Line of Credit.
ICF will manufacture six DEMU rakes consisting of 78 coaches in five variants. The order is being jointly executed by RITES and ICF under the India-Sri Lanka economic cooperation agreement.
41 - India conducted special training programme for Maldivian civil servants

India conducted a two-week special training programme for Maldivian civil servants in Delhi and Mussoorie as a part of a bilateral MoU on Training and Capacity Building Programme between the National Centre for Good Governance (NCGG) and the Maldives Civil Service Commission (CSC).
Prime Minister Narendra Modi, during his visit to the Maldives in June, had emphasised India's Neighbourhood First policy. The MoU envisages capacity building activities for 1,000 civil servants of the Maldives at the National Centre for Good Governance over the next five years.
42 - President of India in Slovenia; Attends Bilateral Meetings; Leads Delegation Level Talks

The President of India, Shri Ram Nath Kovind reached Ljubljana, Slovenia and discussed possible collaboration between the two nations on a wide range of issues such as high technology, especially clean technology, robotics and artificial intelligence. On the issue on Climate change and environment, the President urged Slovenia to join the International Solar Alliance and strengthen India’s efforts to combat climate change.
India and Slovenia signed and exchanged seven MoUs and Programmes of Cooperation in the fields of Investment, Sports, Culture, River Rejuvenation (Clean Ganga Mission), Science & Technology and Standards in the presence of the two Presidents.
43 - UNESCO announced to publish anthology of Guru Nanak Dev’s writing in world languages

United Nations Educational, Scientific and Cultural Organization (UNESCO) has decided to translate and publish an anthology of the writings of Guru Nanak Dev in world languages to mark his 550th birth anniversary.
Indian government will hold a series of events and has initiated projects to mark 550th birth anniversary of Guru Nanak Dev such as construction of Kartarpur Corridor from Dera Baba Nanak in Gurdaspur district, development of the historic town of Sultanpur Lodhi as a heritage town, upgradation of Sultanpur Lodhi railway station and release of commemorative coins and postage stamps.
44 - Bangladesh PM instructs government officials to fly by Biman Bangladesh Airlines

Bangladesh Prime Minister Sheikh Hasina has announced that government officials must fly by Biman Bangladesh Airlines on the routes where the government-run carrier operates flights.
Bangladesh inducted the fourth Boeing-787-8 dreamliner Rajhangsha in the Biman Bangladesh fleet at the Shahjalal International Airport in Dhaka. With the new aircraft, the fleet strength of Biman Bangladesh has gone up to 16. It is part of a 2.1-billion-dollar agreement signed with Boeing in 2008 to purchase 10 new aircraft.
45 - Sri Lanka unveiled South Asia’s tallest tower

Sri Lanka unveiled South Asia’s tallest tower built at a cost of over $100 million, 80% of which has been funded by China under the controversial Belt and Road Initiative (BRI).
The 350-metre-tall 17-storey Lotus Tower comprises a television tower, a hotel, a telecommunications museum, restaurants, auditorium, an observation deck, a shopping mall and a conference centre. Sri Lanka and China signed the Lotus Tower agreement in 2012, with China National Electronics Import and Export Corporation (CEIEC) being the general contractor.
46 - 55th ITEC Day celebrated in Dhaka

The 55th Indian Technical and Economic Cooperation (ITEC) Day was celebrated at the High Commission of India in Dhaka, Bangladesh. Around 300 ITEC alumni attended the programme. ITEC offers opportunities to participants to avail of short and medium term courses in premier institutions like IITs and IISCs in India. It was instituted in 1964 as part of India’s Development Assistance offering for developing countries.
Every year more than 10,000 training slots are offered to 161 partner countries for training courses in various areas.
47 - India announced 12 million dollar grant to Pacific Island countries

Prime Minister Narendra Modi met leaders of the Pacific Islands Developing States (PSIDS) on the sidelines of the UNGA session in New York and announced allocation of 12 million US Dollar grant towards the implementation of high impact developmental project in the area of their choice.
In addition, a concessional Line of Credit of 150 Million dollars which can be availed by the PSIDS for undertaking solar, renewable energy and climate-related projects based on each country’s requirement was announced.
48 - Bangladesh, Myanmar & China to form tripartite mechanism for Rohingya Repatriation

Bangladesh, Myanmar and China have agreed to form a tripartite joint working mechanism to oversee the repatriation process of Rohingyas to Myanmar. The proposal was mooted by China which was also agreed to by Myanmar and Bangladesh.
Bangladesh and Myanmar had signed two agreements in November 2017 for repatriation of the Rohingyas within two years but two repatriation attempts have failed as the Rohingyas refused to return without the guarantee of citizenship and safety in Myanmar.
49 - World’s first camel hospital at Dubai set to expand its facilities

World’s first camel hospital at Dubai is set to expand its facilities by an additional 50%. It is a unique hospital catering specifically to the needs of the burgeoning camel industry. The camel hospital, built at an estimated cost of 40 million Dirhams, opened in 2017 to meet the demand in the UAE for an advanced medical facility dedicated to treating camels.
Camels are an integral part of the United Arab Emirate’s heritage. Historically, camels, known as the ‘Ship of the Desert’ were a source of transport as well as food and milk in the region.
50 - International tour operator Thomas Cook collapsed

International tour operator Thomas Cook has collapsed after last-minute negotiations aimed at saving the 178-year-old holiday firm failed. The firm collapsed after it failed to meet the demand of the Royal Bank of Scotland and a range of other banks to pay them 250 million US dollar.
Since May 2018, shares have fallen by more than 96% amid Brexit uncertainty and intense competition in the tourism sector. Cabinet maker Thomas Cook created the travel firm in 1841.
51 - Abu Dhabi awards licences to 18 non-Muslim places of worship

The Department of Community Development (DCD) in Abu Dhabi has awarded licences for the existing 18 non-Muslim places of worship in the Emirate of Abu Dhabi; 17 churches and the BAPS Hindu Mandir which is under construction in Abu Dhabi.
The country’s Christian population currently stands at 13%. There are two Hindu temples in Dubai — to accommodate the roughly 3.3 million Indians in the country — and one Sikh gurdwara. Construction of Abu Dhabi’s first Hindu temple is currently underway, and is expected to open its doors in 2020.
52 - Prime Minister announced Coalition for Disaster Resilient Infrastructure

Prime Minister of India, Shri Narendra Modi, announced a global Coalition for Disaster Resilient Infrastructure (CDRI), at the UN Climate Action Summit 2019 held in New York City, USA.
Developed through consultations with more than 35 countries, CDRI envisions enabling measurable reduction in infrastructure losses from disasters, including extreme climate events. CDRI will provide member countries technical support and capacity development, research and knowledge management, and advocacy and partnerships to facilitate and encourage investment in disaster resilient infrastructure systems.
53 - ‘Gully Boy’ selected as India’s official entry to Oscars 2020

The Film Federation of India (FFI) has chosen ‘Gully Boy’ as India’s official entry to the Oscars. The film was directed by Zoya Akhter and the lead cast featured Ranveer Singh and Alia Bhatt.
Celebrated actor-filmmaker Aparna Sen was the head of the jury for this year’s selection committee. The last Indian film that made it to the final five in the Best Foreign Film category list was Ashutosh Gowariker’s “Lagaan” in 2001. No Indian film has ever won an Oscar.
54 - 64th Commonwealth Parliamentary Conference held in Uganda

The 64th Commonwealth Parliamentary Conference 2019 was held at Kampala, Uganda and was hosted by the Parliament of Uganda. The Commonwealth Parliamentary Conference is one of the largest gatherings of Commonwealth parliamentarians and is a unique and valuable opportunity to network with legislators for shared-learning and to build diplomatic relations.
The theme of this year's conference was: "Adaption, engagement and evolution of parliaments in a rapidly changing Commonwealth".
55 - "Howdy, Modi!" event in Houston, Texas

Prime Minister Narendra Modi attended the "Howdy Modi" event organised by the non-profit Texas India Forum at the NSG stadium in Houston, Texas. US President Donald Trump too parrtcipated in the event. The tagline of the event was 'Shared Dreams, Bright Futures'.
The event witnessed the largest gathering ever with over 50,000 Indian-Americans, for an elected foreign leader visiting the US. It threw light on the tremendous contribution of Indo-Americans in United States and the strong and lasting partnership between the US and India.
56 - Saudi Arabia to offer tourist visas for first time

Saudi Arabia will offer tourist visas for the first time opening up the kingdom to holidaymakers as part of a push to diversify its economy away from oil. It will open applications for online tourist visas to citizens of 49 countries. Visas are currently restricted to expat workers, their dependents and Muslim pilgrims travelling to holy sites in Mecca and Medina.
The kingdom will ease its strict dress code for foreign women, allowing them to go without the body-shrouding abaya robe that is still mandatory public wear for Saudi women.
57 - The World University of Design hosted 3rd - edition of Global Goals Jam

The India edition of the Global Goals Jam 3.0 (GGJ) was successfully conducted from September 20 to 21 by the World University of Design (WUD). This year's theme focused on the growing issue of #eWaste. It is in-line with #SDG12 - Responsible consumption and ethical production.
World University of Design (WUD) is India's first and only University dedicated to education in the creative domain. GGJ is an international platform for inclusive learning where people from all around the world contribute to the 17 global goals for sustainable development of UNDP.